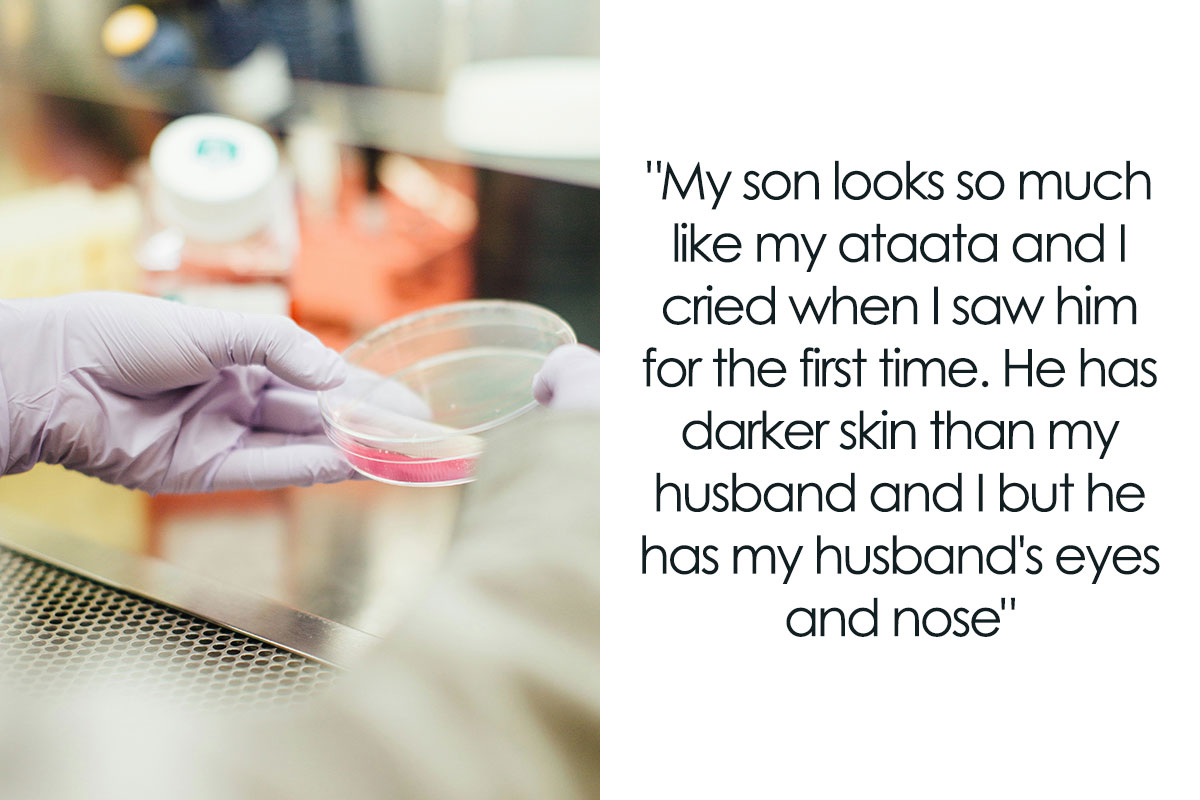

Friends, relatives in the end, their own family.
We have told you similar stories more than once, now its time to tell you another one.
However, the babys eyes and nose were exactly like his fathers.
The author was shocked by this demand, but gave in to the spouses pressure.
However, the trend itself of demanding paternity tests definitelyexists nowadays.
When selling fire extinguishers, start by talking about the fire.

And this is where marketing comes to the rescue.
In fact, the answer is very simple.
Isnt it true that everything looks completely different now?

But the so-called real non-paternity rate in the USA is much less scary.
But 3.3 percent wont give the desired sales volume.
More precisely, to commenters opinion about him.

And this opinion is quite disappointing.
The utter disrespect your husband showed and continues to show is alarming, one of the commenters simply wrote.
Check out the results:


















